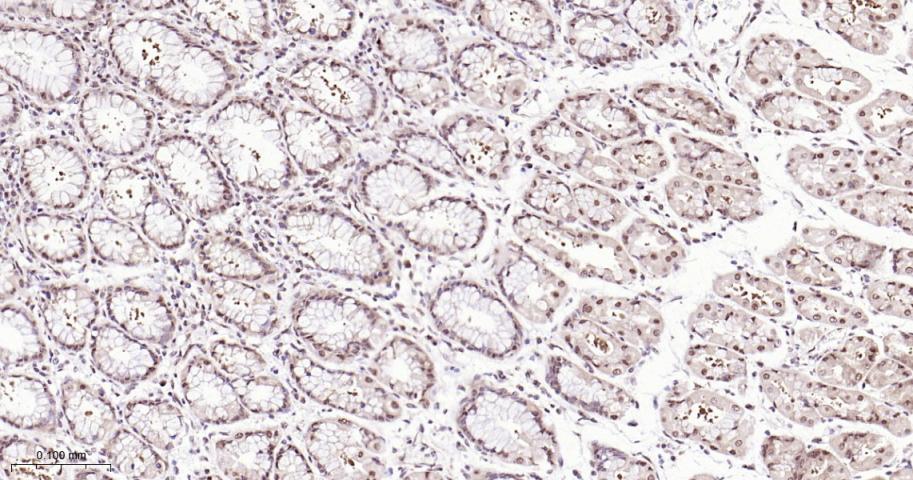
环指蛋白75重组兔单抗

环指蛋白75重组兔单抗
Rrmab?兔单抗

货号:bsm-60704R
产品详情
相关标记
相关产品
相关文献
常见问题
概述
产品编号
bsm-60704R
产品类型
重组兔单抗、mIHC精品抗体
英文名称
RBX1 Recombinant Rabbit mAb
中文名称
环指蛋白75重组兔单抗
英文别名
BA554C12.1; RNF75; ROC1; 1500002P15Rik; RBX1_HUMAN; RBX1; E3 ubiquitin-protein transferase RBX1; Protein ZYP; RING finger protein 75; RING-box protein 1 (Rbx1); Regulator of cullins 1 (ROC1); 2.3.2.27; 2.3.2.32; RBX1_MOUSE;
抗体来源
Rabbit
免疫原
A synthesized peptide derived from human RBX1: 60-108/108
亚型
IgG
性状
Liquid
纯化方法
affinity purified by Protein A
克隆类型
Recombinant
克隆号
R2D3
理论分子量
12 kDa
浓度
1mg/ml
储存液
0.01M TBS (pH7.4) with 1% BSA, 0.02% Proclin300 and 50% Glycerol.
研究领域
Cell Biology > Proteolysis / Ubiquitin > Proteasome / Ubiquitin > Ubiquitin E3 Enzymes > SCF Complex E3 Ligase
Epigenetics and Nuclear Signaling > Ubiquitin & Ubiquitin Like Modifiers > E3 Ubiquitin Ligases
Epigenetics and Nuclear Signaling > Ubiquitin & Ubiquitin Like Modifiers > Ubiquitin like Modifiers
SWISS
Gene ID
保存条件
Shipped at 4℃. Store at -20℃ for one year. Avoid repeated freeze/thaw cycles.
注意事项
This product as supplied is intended for research use only, not for use in human, therapeutic or diagnostic applications.
数据库链接
背景资料
This locus encodes a RING finger-like domain-containing protein. The encoded protein interacts with cullin proteins and likely plays a role in ubiquitination processes necessary for cell cycle progression. This protein may also affect protein turnover. Related pseudogenes exist on chromosomes 2 and 5.[provided by RefSeq, Sep 2010]

产品应用
| 应用 | 已检合格种属 | 预测种属 | 推荐稀释比例 |
|---|---|---|---|
| WB | Human, Mouse, Rat | 1:500-2000 | |
| IHC-P | Human, Mouse, Rat | 1:100-500 | |
| IHC-F | Human, Mouse, Rat | 1:100-500 | |
| IF | Human, Mouse, Rat | 1:100-500 | |
| Flow-Cyt | Human | Mouse, Rat | 1:50-100 |
| ICC/IF | Human | Mouse, Rat | 1:50-200 |
交叉反应
交叉反应: Human, Mouse, Rat
相关产品
暂无相关产品
靶标
基因名
RBX1
蛋白名
E3 ubiquitin-protein ligase RBX1
亚基
Part of a SCF complex consisting of CUL1, RBX1, SKP1 and SKP2. Part of a SCF-like complex consisting of CUL7, RBX1, SKP1 and FBXW8. Part of CBC(VHL) complexes with elongin BC complex (TCEB1 and TCEB2), CUL2 or CUL5 and VHL. Part of the CSA complex (DCX(ERCC8) complex), a DCX E3 ubiquitin-protein ligase complex containing ERCC8, RBX1, DDB1 and CUL4A; the CSA complex interacts with RNA polymerase II; upon UV irradiation it interacts with the COP9 signalosome and preferentially with the hyperphosphorylated form of RNA polymerase II. Part of multisubunit E3 ubiquitin ligase complexes with elongin BC complex (TCEB1 and TCEB2), CUL2 and MED8; elongin BC complex (TCEB1 and TCEB2), CUL5 and MUF1. Part of multisubunit complexes with elongin BC complex (TCEB1 and TCEB2), elongin A/TCEB3 or SOCS1 or WSB1 and CUL5. Interacts directly with CUL1 and probably also with CUL2, CUL3, CUL4A, CUL4B, CUL5 and CUL7. Probably interacts with CDC34. Interacts with COPS6. Component of the DCX DET1-COP1 ubiquitin ligase complex at least composed of RBX1, DET1, DDB1, CUL4A and COP1. Part of an E3 ligase complex composed of RBX1, DDB1, DDB2 and CUL4A or CUL4B. Interacts with UBE2M. Part of a SCF complex consisting of CUL1, FBXO3, RBX1 and SKP1; this complex interacts with PML via FBXO3. Interacts with human adenovirus early E1A protein; this interaction inhibits RBX1-CUL1-dependent elongation reaction of ubiquitin chains by the SCF(FBW7) complex. Component of the SCF(Cyclin F) complex consisting of CUL1, RBX1, SKP1 and CCNF. Identified in a SCF (SKP1-CUL1-F-box protein) E3 ubiquitin ligase complex together with HINT1 and CDC34. Component of multiple BCR (BTB-CUL3-RBX1) E3 ubiquitin-protein ligase complexes formed of CUL3, RBX1 and a variable BTB domain-containing protein. Part of the BCR(ENC1) complex containing ENC1. Part of the BCR(GAN) complex containing GAN. Part of the BCR(KLHL41) complex containing KLHL41. Part of the BCR(KEAP1) complex containing KEAP1.
亚细胞定位
Cytoplasm. Nucleus.
组织特异性
Widely expressed.
相似性
Belongs to the RING-box family.
Contains 1 RING-type zinc finger.
Contains 1 RING-type zinc finger.
功能
E3 ubiquitin ligase component of multiple cullin-RING-based E3 ubiquitin-protein ligase complexes which mediate the ubiquitination and subsequent proteasomal degradation of target proteins, including proteins involved in cell cycle progression, signal transduction, transcription and transcription-coupled nucleotide excision repair. The functional specificity of the E3 ubiquitin-protein ligase complexes depends on the variable substrate recognition components. As a component of the CSA complex promotes the ubiquitination of ERCC6 resulting in proteasomal degradation. Through the RING-type zinc finger, seems to recruit the E2 ubiquitination enzyme, like CDC34, to the complex and brings it into close proximity to the substrate. Probably also stimulates CDC34 autoubiquitination. May be required for histone H3 and histone H4 ubiquitination in response to ultraviolet and for subsequent DNA repair. Promotes the neddylation of CUL1, CUL2, CUL4 and CUL4 via its interaction with UBE2M. Involved in the ubiquitination of KEAP1, ENC1 and KLHL41.
标记抗体
暂无标记数据
同靶标产品
暂无同靶标产品
相关文献
提示: 发表研究结果有使用 bsm-60704R 时请让我们知道,以便我们可以引用参考文章。作为回馈,资料提供者将获得我们送上的小礼品。
暂无相关文献
常见问题
暂无常见问题